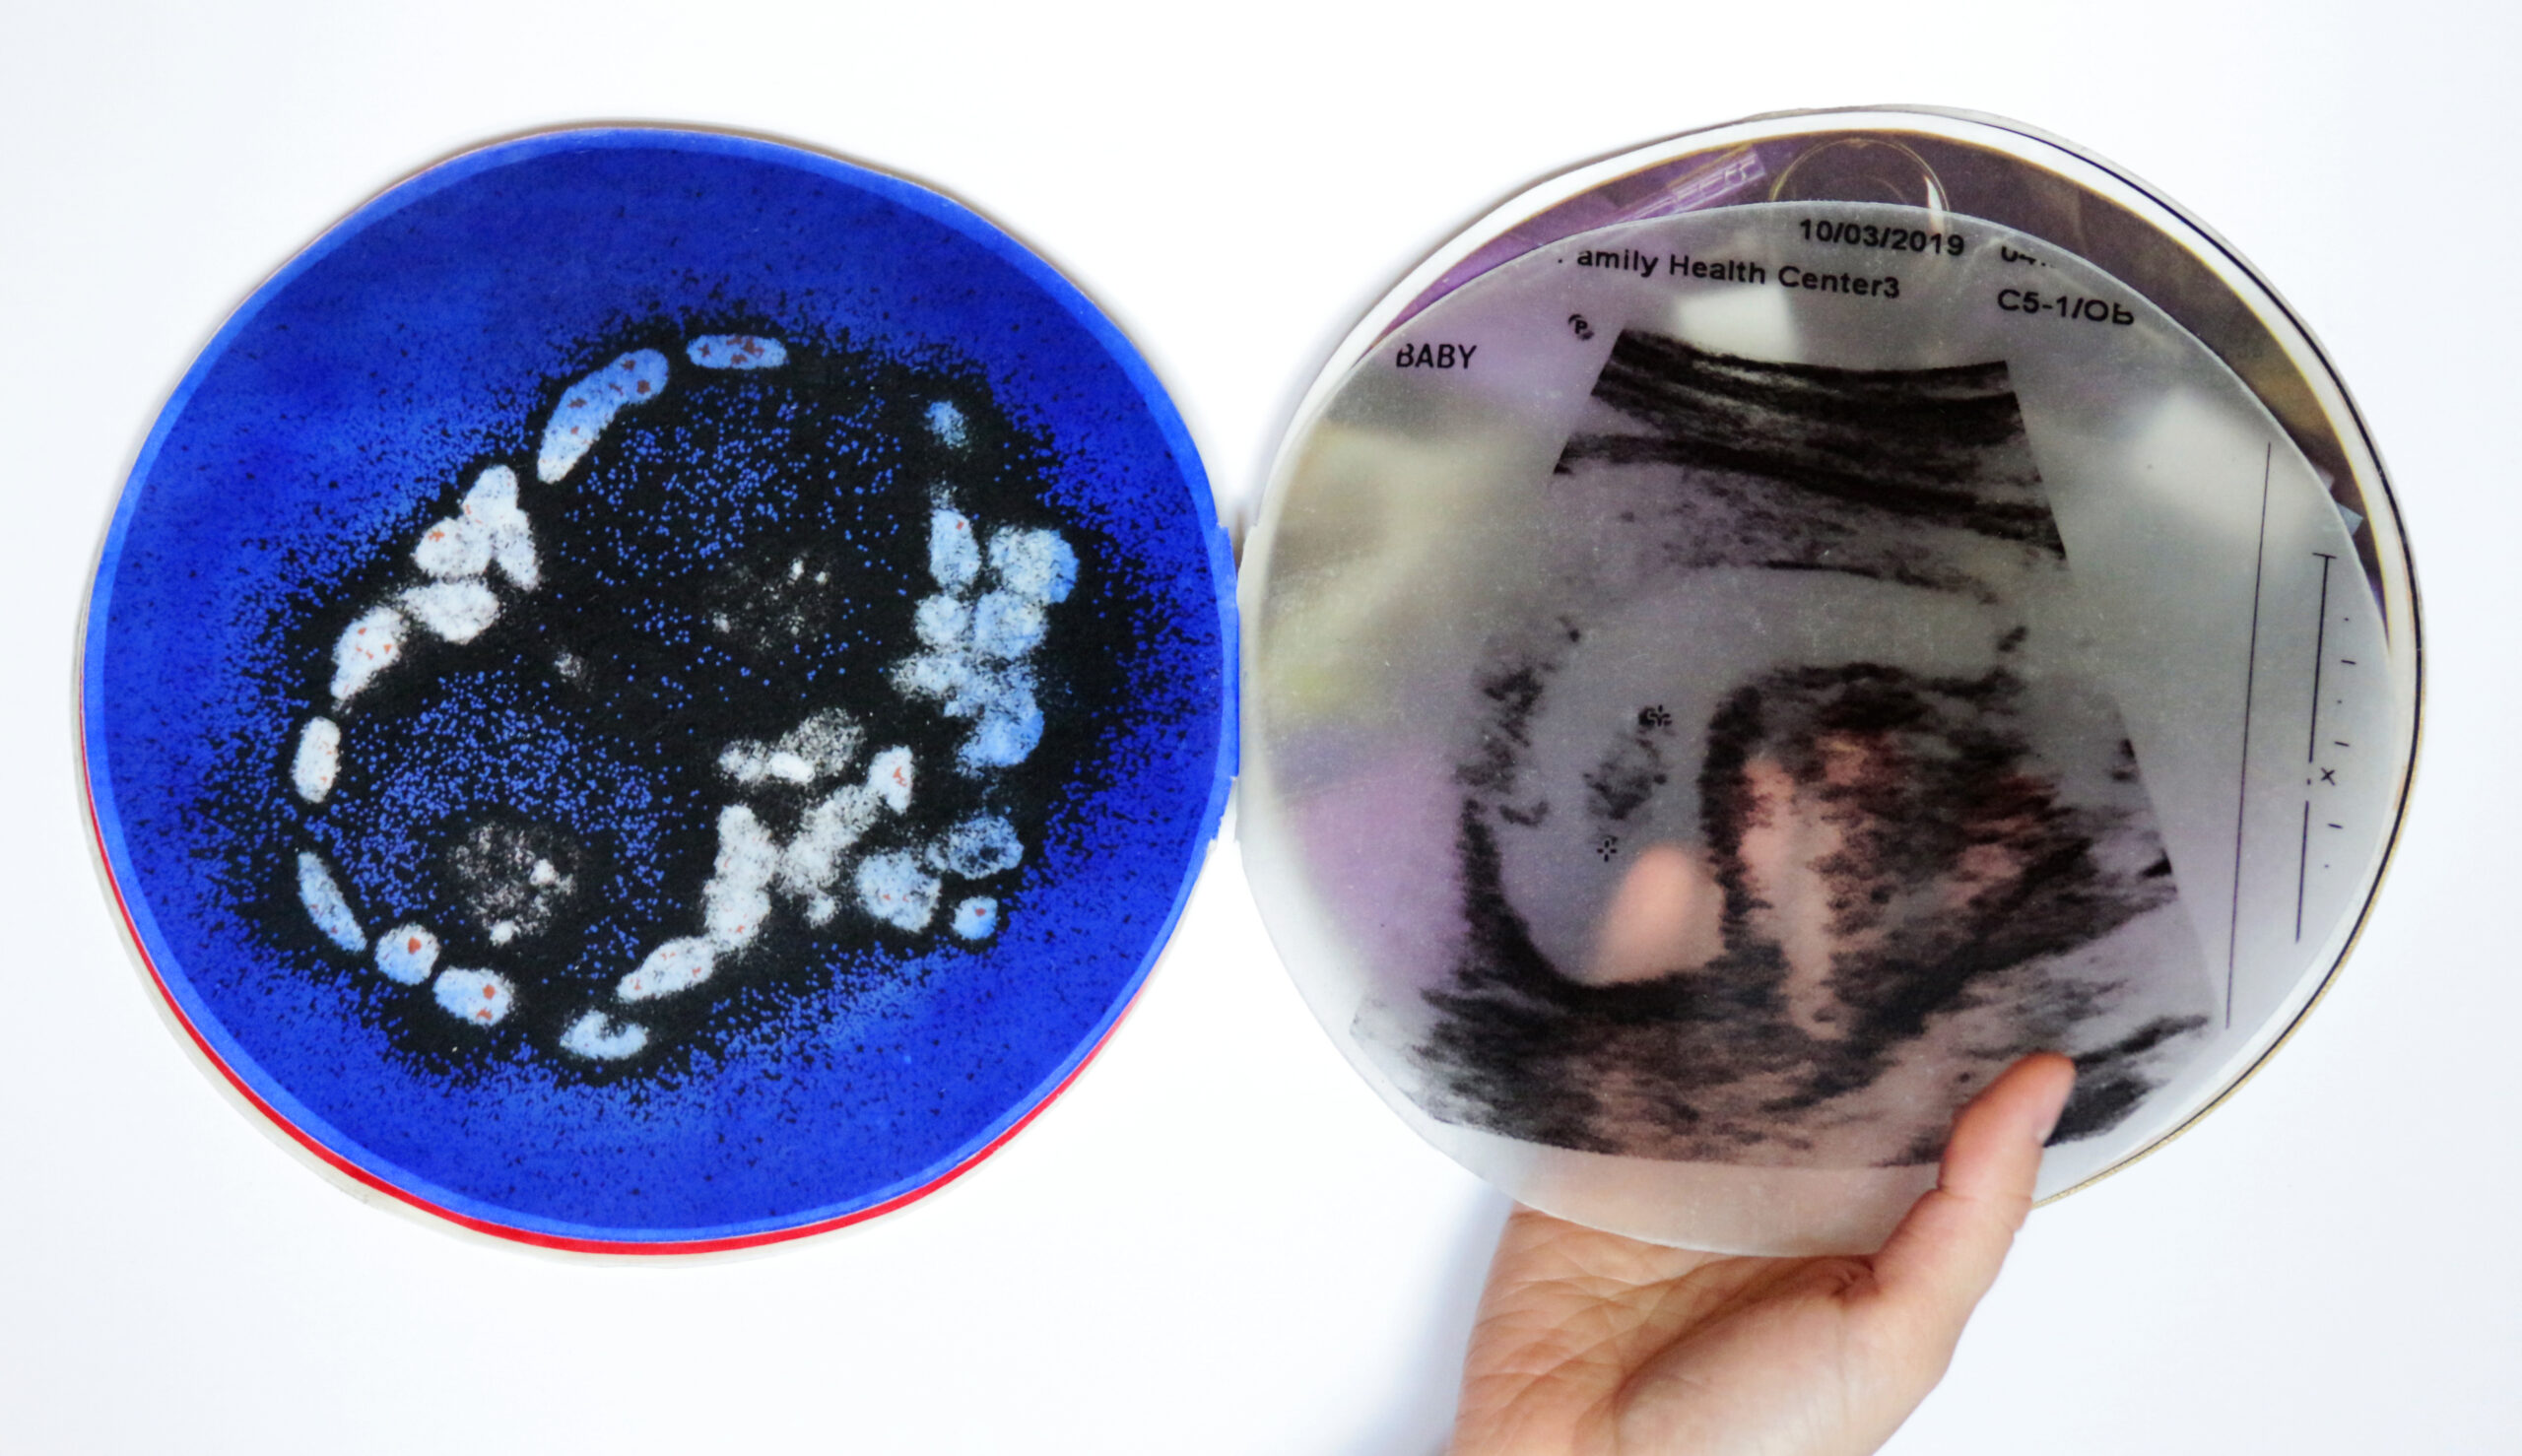

Lab Rats and Book Bodies: Creating Intersubjectivity for Patients and Practitioners
doi: 10.18737/0607291066
AMA Citation: Stahl DG. Lab Rats and Book Bodies: Creating Intersubjectivity for Patients and Practitioners. J Hum Rehabil. 2025; Fall. doi:10.18737/0607291066
Table of Contents
Introduction
The labyrinthine basement of a biomedical research laboratory is an unlikely place to find an artist. In 2019, I pursued an artist residency at the McGill University Fertility Research Laboratory to better understand the mechanisms of ovulation that seemed to be failing my sister’s attempts at conception and motherhood, in addition to the other ways her body continued to oppose her will. My goal was to procure source material for a person visualizing infertility while also living with chronic illness. What I had not expected was the expansion of this arts-based research to envelop not only the scientists working in this lab, but the lab mice also residing in this space. The final format of the artwork as a handmade book promotes an intersubjective experience of illness and health, as readers use their bodies to engage with the voices and unique materials held within this multi-sensory medium. The outcomes of this residency, along with numerous other artworks featured in my recently published book, Embodied Books: Experiencing the Health Humanities Through Artists’ Books (Figure 1), make ‘sense-able’ to healthcare workers, learners, and the general public the extraordinarily complicated issues of ethics and agency when it comes to medical care.

Humans as Lab Rats?
Where does the feeling of “being treated like a lab rat” come from? In our collective imaginations of what science looks like, how do laboratory processes remind us of our own experiences moving through healthcare systems? Is it like being palpated and prodded, looked on as an object of study, or subjected to painful tests? It may be the sense that our test results matter more than our testimonies, or that our bodily autonomy is forfeited to the hands of professionals. In all of these instances, forgoing agency in the pursuit of healing leaves us feeling a little less than human. Somewhere in our vague notions for how healthcare operates, we share a sense of empathy with the laboratory rodent.
My sister knows this feeling more than most. Dr. Devan Stahl, hospital chaplain, Professor of Clinical Ethics, and multiple sclerosis (MS) patient, intimately understands the patient perspective. When she was first diagnosed with MS as a divinity school graduate student in 2008, she signed up for a four-year medical trial for the 50-50 chance to receive medications that she could not otherwise afford. In her illness narrative, Devan shares an instance of rodent empathy: “I was not receiving medical care; I was a guinea pig. I was testing a product.”1(p10) Statements like this reflect the dehumanization and voicelessness patients may feel when entering healthcare systems.
For centuries, physicians have played a role in stigmatizing the disabled by pathologizing difference itself, casting those outside the bounds of “ableness” as potentially diseased and in need of separation from the rest of society.2 Even today, a narrow biomedical lens categorizes disability as “less than” or as a problem to be fixed, rather than as part of the typical human experience that, despite outsider perceptions, can still encompass well-being and a meaningful, good life.3 These perceptions have also permeated general society. The bodies of the ill and disabled illicit pity, fear, or disgust, feelings evidenced by a set of discriminatory ordinances in the 19th and 20th centuries known as the “Ugly Laws,” which sought to keep those deemed unaesthetic hidden away from the eyes of more ordinary publics.4 Although disability will eventually affect most people if we live long enough, the stigma still drives us to hide our own, seek surgery, wear prosthetics, or sequester people in asylums or homes.
Laboratory animals are also kept away from public view. Devan’s sentiment of being treated like an animal rung in my ears as I witnessed the literal procedures of animal testing in the lab. I shadowed my scientist collaborators, Sophia Granados Apirici and Karen Carvalho, for three months as they conducted their experiments on mice ova, and sometimes on human ova when they were donated to the lab, in the hopes of developing a therapy that would prolong women’s fertile years. I joined the scientists as they gathered the tiny ovaries from mice housed in clear plastic cages, next to hundreds of other plastic cages, within a locked room, at the end of a maze of locked corridors, down an elevator, and under the feet of those whose lives and well-being may depend upon the discoveries deep within rodent anatomy. Although lab mice form a cornerstone of scientific discovery, they tend to be hidden in basements. The secretive aspect of this work is not to necessarily safekeep the intellectual property of their methods or outcomes, but to address the taboo nature of the research practice itself. Once the scientists dissected the organs, we walked them back upstairs to a room with windows.
The Artist in the Lab
I attained this artist residency in the hopes of unveiling and visualizing new complexities surrounding identity and illness through artists’ books, which was the focus for my arts-based PhD in Humanities. I had been working in the broad and interdisciplinary field of medical/health humanities for almost 10 years at this point, focused on representing my sister’s patient experiences through multi-sensory printmaking and bookmaking. However, I had never conducted this research-creation in scientific or laboratory contexts. I imagined I could merge Devan’s biomedical scans with aesthetic signifiers I found in this laboratory in order to express a lineage of biomedical innovation and the promise of a healthier tomorrow. While the project began as an attempt to materialize one woman’s experience, my time in the lab ultimately expanded to include many more subjects entangled in the process of scientific innovation—human and animal alike.
Artist and writer Sanaura Taylor also grapples with the intersection of disability and animals. Taylor portrays her nude body, with her bent back and curved arms, among animals who have similar body shapes to her own: chickens, walruses, or farm animals that share her diagnosis of arthrogryposis.5 She states that this work is not meant to compare disability to animals, but “rather to compare our shared oppressions,” as “disabled people and nonhuman animals… are often oppressed by similar forces.”6(p762)
The Medical Gaze
Part of this oppression shared by patients and animal models is the medical gaze.7 Proposed by Michel Foucault and expanded upon by disability scholars like Rosemarie Garland-Thomson, the medical gaze is an objectifying stare and suppresses the humanity and agency of the patient.2,7 Looking at the patient as an object of study rather than an animate, conscious being, the medical gaze can oppress all those under its eye to a state of “less than.”
Illness scholars like Havi Carel explain the oscillation of perception between object and subject within a clinical encounter. Physicians or rehabilitation practitioners may temporarily objectify (parts of) their patients’ bodies in order to cope with the moral distress of an uncomfortable examination or painful treatment process.3 Afterwards, we expect our healers to reconstitute the ailed, objectified parts of our body back into the perception of our full, wholistic subject-hood. However, this transition may not be as seamless as we would hope. The suspicion that health practitioners continue to view their patients as at least partially less than whole engenders distrust and dissatisfaction in healer-patient relationships.
For their part, the scientists I worked with showed extreme care for their mice to minimize any suffering. They also took immense pride in the potential of their work to help women conceive. Yet, they also stated that euthanizing mice caused them and their colleagues moral distress. I imagine Devan’s physicians may feel a similar kind of ethical strain when they subject her to yet another claustrophobia-inducing MRI scan or question whether or not she was taking the active medication during her medical trial—a shared sense of “this is what must be done” in the pursuit of medicine.
Once the ovaries were dissected, the rest of the mouse was placed within a biohazard bag and dropped into a holding box. This package would soon be picked up by a laboratory assistant and taken to the incinerator. Observing the extraction of scientifically-valuable portions of the mice and then the disposal of the rest further resonates with patient sentiments of feeling “reduced” in the eyes of their healthcare workers. It is as though blood test results, electrocardiogram readings, or biomedical scans speak with more authority than the patient herself. As Devan shares, “For the neurologist who first diagnosed me, the MRI became the way he saw me. …Within the health-care system, my body became an object of medical inquiry to be measured and assessed.”8(pp498-499) The patient’s entire being is reduced to a fraction of herself, that which is considered medically significant, leaving the rest estranged from the wholeness of the self.
Mouse and Human Celestial Bodies
With the ovum now luminesced by the microscope’s lasers, the scientists hope to collect useful screenshots of its structures that will prove or disprove their hypotheses. The luminous microscopy of dissected mouse ova and those donated by humans seem interchangeable to my novice eyes when they are viewed in isolation apart from their embodied origins. Ideally, the structures of mouse and human ova would be so similar that they can act as a suitable proxies for each other when assessing the results of the experiment. All of the fluorescent organs I witnessed were otherworldly enough to make one forget exactly whose body was put forward as experimental source material. They all appeared like bright celestial bodies floating along in the black expanse of space, uniquely displaying the wear of collisions through an unfathomable journey. The entire catalogue of neon biomatter felt simultaneously less-than- and more-than-human. Beholding the wonder of anatomy prompts reverence from the scientists toward the mice and women donors, in addition to feelings of immense gratitude for their sacrifices.
The esteem from the scientists for the mice complicates the disparaging idiom of “being treated like a lab rat.” While patients feel reduced to less-than-human when they enter medical systems, conversely, biomedical science elevates mice to the status of near-human when they hope to substitute their anatomy for our own in the pursuit of innovative treatments. Both humans and mice are subjected to a potentially disconnecting biomedical gaze from researchers or practitioners; however, the force of this gaze pushes their bodies toward one another to meet somewhere in the middle. The discomforting suspicion that patients are akin to rodents is realized when the dyad of human and animal collapses under the eye of the microscope.
Biomedical Images, Wonder, and New Respect
I propose that creating more opportunities for wonder and reverence for biomedical images might form a basis to restore the subjecthood for patients and rodents alike. This is because “when we behold the other in wonder,” as Garland-Thomson explains, “we find a common bond in our humanity amid the wondrous diversity of creation.”9(p488) Rather than reducing the body to biomedically-significant images, those same images could be expanded into the intersubjective world-building capacities of art. Emplacing these images into handmade artists’ books in particular, I further contend, invites readers to engage beyond the sense of sight and to wonder through an aesthetic touch. The delicate, healing touch of healthcare practitioners negates an objectifying gaze because the warmth and animation of another’s self cannot be denied.3 Handmade books invite a similar gentle touch, as the delicate papers or intricate navigation require a slow and care-full read.
A book is not a whole person, just as a medical image is not a whole person. However, handmade books, particularly those made about lived experiences, have the potential to form an approximate intersubjective experience. Intersubjectivity, that is, the exchange of consciousness through dialogue or the senses, can help us to re-view one another as whole beings, and underpins the formation of empathy. When the patient’s body and voice are not present at hand, their handmade books extend their consciousness apart from the self. While makers object-ify their bodies into books, they are not static objects. Their shareability make handmade books capsules for consciousness made present and enlivened every time one opens their covers.
Bodily Proxies
After my residency in the laboratory, it seemed less strange that a handmade book could stand in for a human body. The core proposition of the research that eventually became Embodied Books: Experiencing the Health Humanities Through Artists’ Books is that a handmade book might become a bodily proxy for its maker. In addition to the parallel components of anatomy between books and bodies (spine, face, back, head, foot, etc.), opening the covers of a book feels as though readers are peeling back the covers of flesh to inspect the intermingling of material and sensory contents within the pages. In contrast to the makers of commercially-produced books, handmade book-makers control every facet of how pages turn, what they weigh, how they feel, which direction to read, and how readers must contort their own bodies to conduct their inspection. Makers may also incorporate alternative or even ephemeral materials to explicate a particular sensation and transmit a tangible sense of the maker’s unique physiology. Finally, books typically also contain text. Rather than an inert anesthetized body, books utter the consciousness of its maker directly to each reader. In this way, the patient’s body can no longer be viewed in isolation from their voice and humanity. Artists’ books thus present an astonishingly human approximation.
Artists’ Books and Disability
Perhaps most importantly, artists’ books on illness and disability are an invitation from the maker to view and understand their lived experiences through their book-bodies. Instead of repeatedly speaking about or putting one’s body on display, which may feel retraumatizing or objectifying, the maker only has to pass their book to another. Although creating a book on sensitive topics and sharing it with family, physicians, and strangers can be a vulnerable experience, it is also empowering to determine the parameters of bodily representation for oneself. The representation of illness or disability now exists apart from the lived body as a mobile media that can be printed in an edition and reside in numerous far-off collections all at once. The books themselves seem to have a self-determined quality as they reach out to be held, opened, and inspected—to open the flesh of the book and discover the awaiting anatomy of experience. This is a much gentler dissection.
The artist’s book that I created from my residency in the lab is not the first to connect healthcare workers and the ill. A chapter of Embodied Books is devoted to the life and practice of bookmaker Martha Hall, who epitomizes the potential of these artworks to form intersubjective connections between patients and physicians. While living under the specter of cancer for 14 years, Hall created her artist’s books to document and express her illness experiences with her family. However, after her doctors told Hall she “failed” to recover after her latest treatment, Hall recorded these interactions as a new artist’s book so that her oncologists might hear back and grapple with their disparaging remarks.10 For one particularly dismissive doctor, it was only after Hall insisted he leave his desk, sit next to her, and read this book together that their relationship could be rebuilt. Although Hall was terminally ill, creating books was an important part of Hall’s rehabilitation and well-being. Her artist’s books were also crucial tools to facilitate open and reciprocal communication, even after her death in 2003. Hall deposited her artist’s books in medical institutions across the United States (US), where they may be incorporated into health sciences and other pre-med curricula. Her books continue to help new generations of healthcare workers to understand patient perspectives and form empathetic relationships with their patients.11
Connecting All Bodies
Following Hall’s legacy, the handmade artist’s book I created from this research, Field Notes: How to Be With, (2020), (Fig. 2), attempts to evoke intersubjective connections between all bodies involved in medicine. Field Notes employs transparent pages, created by dipping thin sheets of silk into beeswax, so that readers may view several bodies all at once: the embroidered outline of a lab rat (Fig. 3); imagery of the scientists’ gloved hands (Fig. 4); and Devan’s biomedical scans (Fig. 5); as well as the readers’ own hands as they hold and turn the pages. This mix of bodies implicates those involved in the processes of research and healthcare from beginning to end.

Although a reader may not currently identify as an ill person or patient, it is probably only a matter of time before we all find ourselves passing through hospital doors. Likewise, the foundations of biological and pharmacological knowledge from which we all benefit are largely built upon discoveries derived from animal anatomy and experimentation. Rather than obfuscate these uncomfortable truths, Field Notes honors the innumerable bodies entangled within medicine’s past, present, and future.
The construction of this transparent book prompts readers to engage with their relationships to medicine, health, and illness. In the proxies between science and art or human and animal, layering bodies onto one another, and viewing surface and internal realities together, what new knowledge can we gather about the processes of healthcare? How might a patient view herself when her biomedical scans are seen through a golden visage of the laboratory mouse? How might a physician recalibrate notions of dehumanization with the more-than-human? Might a new, gentler kinship form between beings?
Expanding Experiences, Challenging Boundaries
Like Hall’s work, Field Notes is now deposited in four learning institutions in the US and Canada. It is also incorporated into bookmaking workshops with mixed groups of medical professionals and learners aimed at forming intersubjective experiences of illness. Engaging with and even making their own books on illness creates a safe space for healthcare practitioners to address the emotionally-laden aspects of medical care. In the library archives or bookmaking studio, without pressures to cure or fix the patient, readers can simply touch and be touched by the stories they hold.
The artwork from my time in the lab employs multi-sensory aesthetics to bring renewed attention to the invisible processes of science and healthcare—either because they are so habituated in our society that we no longer notice them or they are purposefully hidden from sight—and how they connect with the lived experiences of illness. Artists’ books also invite readers to behold illness and disability without oppressive stares because the maker retains the power to determine the limits of exposure. The aesthetic qualities of these artworks also transform what may be stigmatized illnesses or disabilities into wonderous forms, evoking contemplation, intersubjectivity, and reverence. Archived and exhibited in learning intuitions for decades to come, these works of art indicate that those found between the covers are worthy to be remembered and even immortalized.
For Field Notes in particular, I aim to challenge the boundaries between bodies by merging patient and rodent in order to reflect on the physical and psychological toll of medical research, not only for all test subjects, but for the researchers as well; and finally, to create space to commemorate and honor all bodies entangled within the processes of healthcare.
References
- Stahl D. Imagining and Imagining Illness. Cascade Books; 2018.
- Garland-Thomson R. Staring: How We Look. Oxford University Press; 2009.
- Carel H. The Phenomenology of Illness. Oxford University Press; 2016.
- Siebers T. Disability Aesthetics. The University of Michigan Press; 2010.
- Taylor S. Portfolio. Available at: https://sunaurataylor.net/portfolio/. Accessed August 10, 2025.
- Taylor S. Vegans, freaks, and animals: toward a new table fellowship. Am Q. 2013;65(3):757-764.
- Foucault M. The Birth of the Clinic. Routledge; 1976.
- Stahl D. Scans and prints. Perspect Biol Med. 2025;67(4):496-506.
- Garland-Thomson R. A call to wonder: reimagining disability. Perspect Biol Med. 2025;67(4):483-495.
- Hall M, Tuttle JS. I Make Books. YouTube. Published 2004. Available at: https://www.youtube.com/watch?v=zQCjsutVAtk. Accessed August 10, 2025.
- Tuttle JS, Miller C. Unruly voices: artists’ books and humanities archives in health professions education. J Med Humanit. 2020;41(1):53-64.
About the Author
Darian Goldin Stahl, PhD MFA
Dr. Darian Goldin Stahl is an interdisciplinary bookmaker and health humanities scholar. In 2024 she founded Embodied Books, which is a bookmaking enterprise that empowers healthcare workers and patients to create handmade books based on their lived experiences of healthcare. Embodied Books emerged from Dr. Stahl’s research as a Banting Postdoctoral Fellow at the UNBC Northern Medical Program. More information can be found on the project website, www.EmbodiedBooks.com, as well as in Embodied Books: Experiencing the Health Humanities Through Artists’ Books, published by Peter Lang International Academic Publishers in 2024.
Dr. Stahl holds a SSHRC Vanier research-creation PhD in Humanities from Concordia University, an MFA in Printmaking from the University of Alberta, and a BFA in Printmaking from Indiana University Bloomington.
Dr. Stahl’s handmade books are included in many prominent permanent collections around the world, such as the Wellcome Collection in London, the Sallie Bingham Center at Duke University, and the Moody Library at Baylor University. More of her work can be viewed at www.DarianGoldinStahl.com.

This work is licensed under a Creative Commons Attribution 4.0 International License.